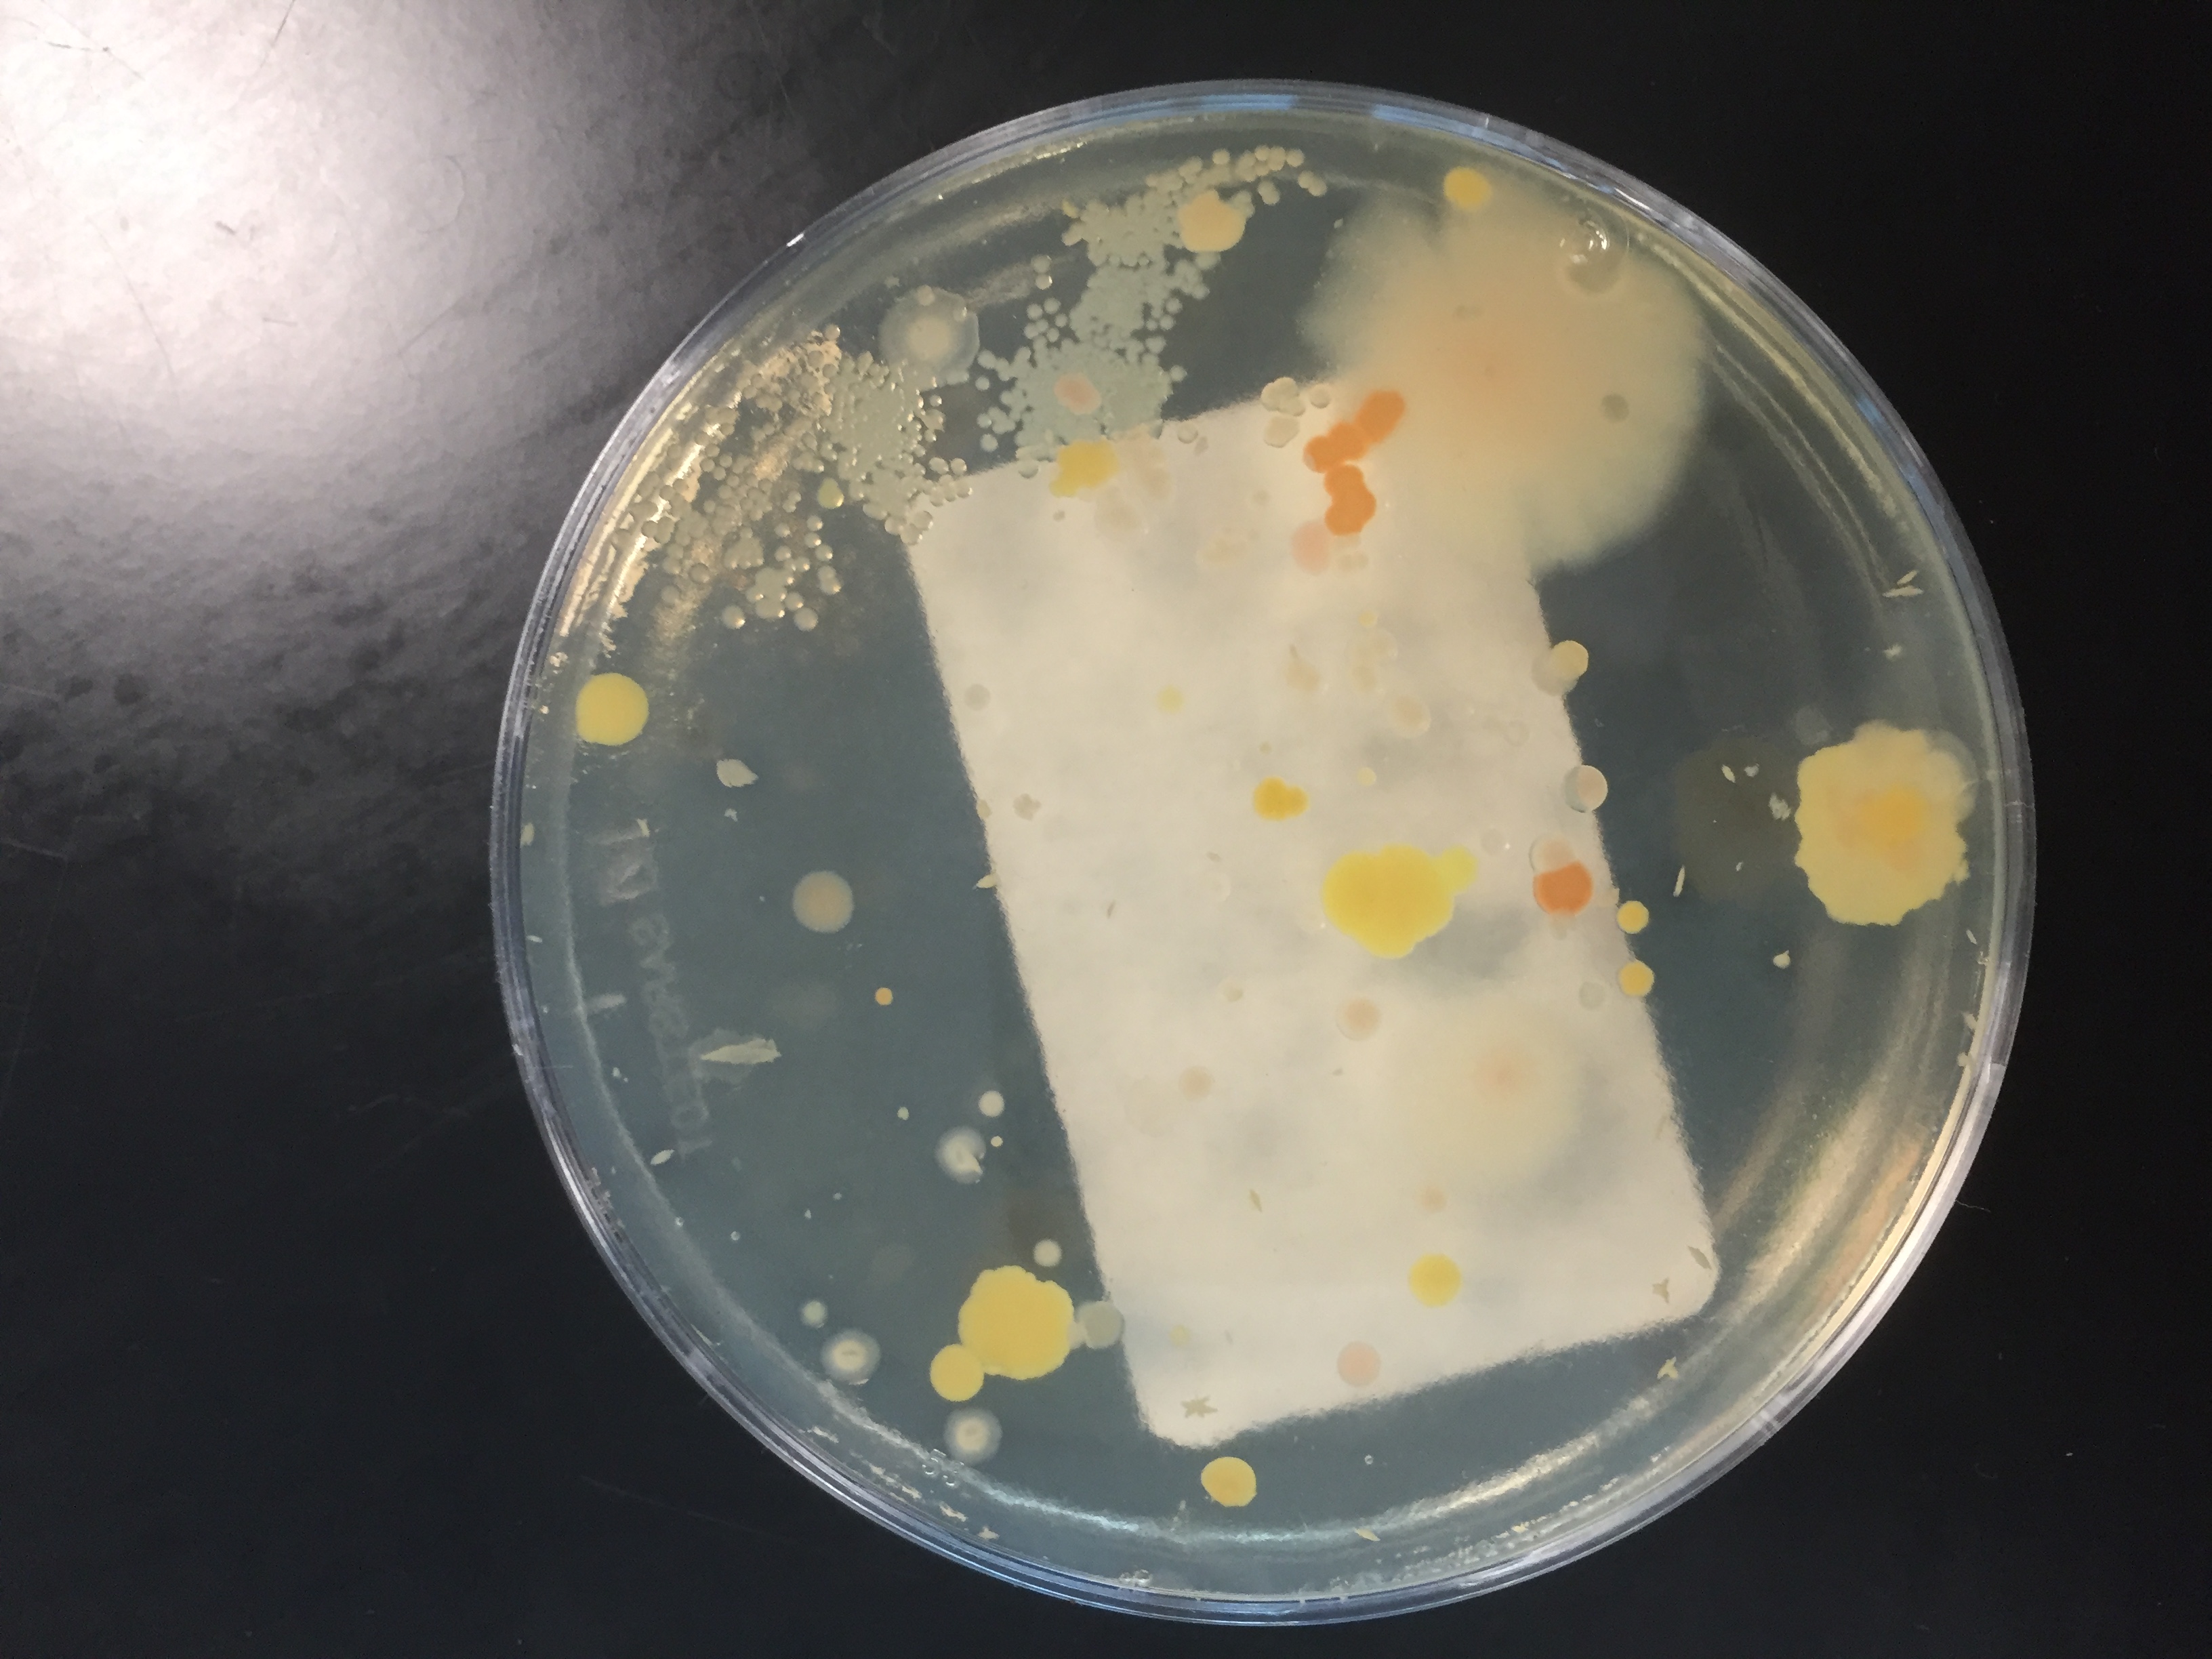

WWW.BIOSIDE.DK
T-KLASSEN 2016-19
Her finder mine elever materialer til brug i undervisningen. På denne side findes især øvelsesvejledninger og forsøgsresultater fra bioteknologiundervisningen.
Billeder fra øvelsen VANDANALYSE 1.T - Feb. 2017.
Billeder fra FlowerPower pilotforsøg d. 20.03.2017.
Mikroskopi.
FPLC.
DNA-prøvetagning.
Fermentor.
"Imagination is more important than knowledge"
Albert Einstein